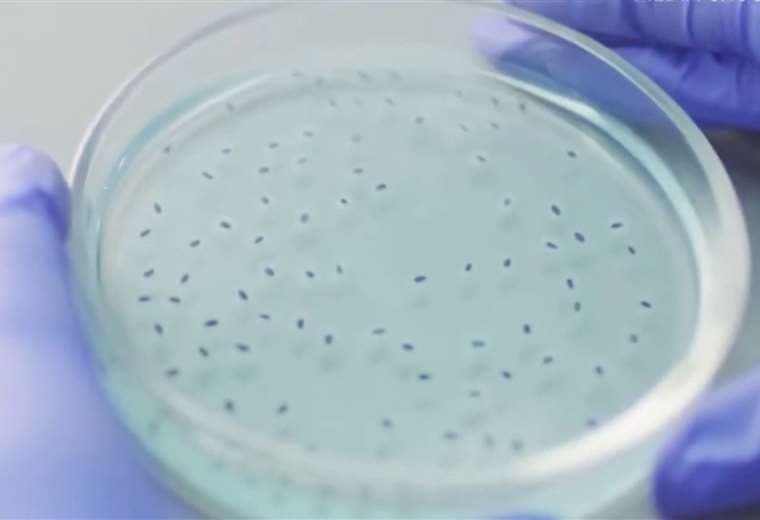

Costa Rica redobla vigilancia en frontera tras confirmarse muerte por Oropouche en Panamá
En ese país ya se reportan 221 casos de la enfermedad, que está a las puertas de entrar a territorio costarricense.
Un hombre de 82 años con enfermedades de fondo se convirtió en la primera víctima por la fiebre del Oropouche en Panamá.
En ese país se reportan ya 221 casos de la enfermedad, que está a las puertas de entrar a territorio costarricense.
Es por eso que en Costa Rica, el Ministerio de Salud hace un llamado para tomar medidas de prevención, sobre todo en la zona fronteriza, y estar vigilantes de posibles síntomas para controlar la infección en caso de que llegue a suelo nacional.
Los pacientes podrían desarrollar síntomas como fiebre, cansancio, escalofríos, malestar general, debilidad, mareos, náuseas y vómitos.
El virus Oropouche es transmitido por la picadura de insectos como culicoides o jején, así como el culex. Por esa razón, la forma de combatirlo es la misma que contra el dengue, eliminando criaderos y usando mosquiteros.